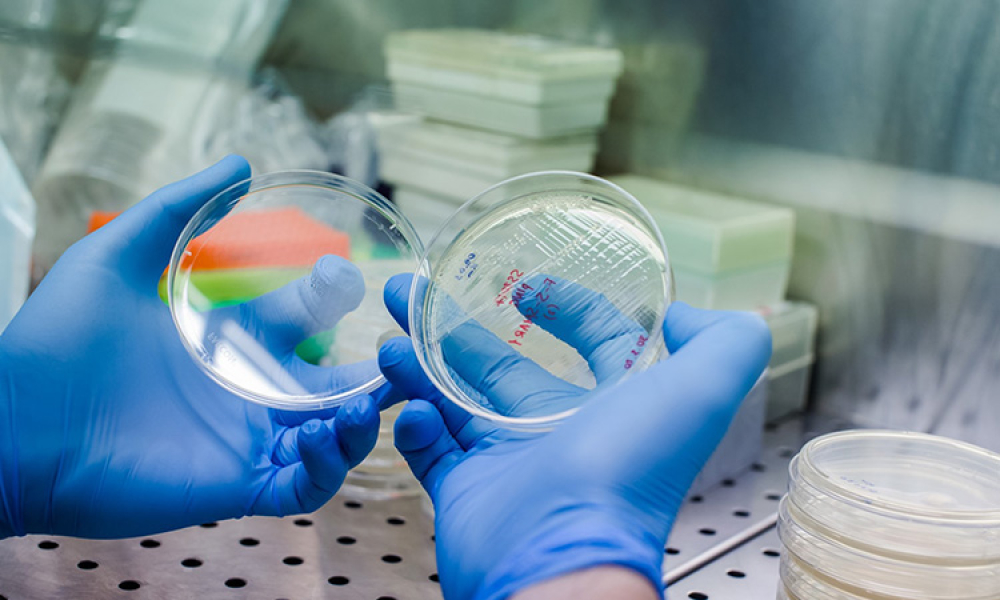
The Need for Speed: Reducing Risk, Cost, and Delays for Novel Gene Therapies

Biotechnology (Biotech) is the application of biological systems and organisms to technical and industrial processes. Pharmaceutical biotechnology is a relatively new and growing field in which the principles of biotechnology are applied to the development of drugs. Most therapeutic drugs in the current market are bioformulations, such as antibodies, nucleic acid products (e.g., mRNA), and vaccines.
Guidance Documents
Advanced Manufacturing (2)
Advanced Therapy Medicinal Products (1)
Biotechnology (6)
- Guide: ATMPs - Allogeneic Cell Therapy
- Guide: ATMPs - rAAV Comparability & Lifecycle Mgmt
- Baseline Guide Vol 6: Biopharmaceutical Manufacturing Facilities 3rd Edition
- Good Practice Guide: Development of Investigational Therapeutic Biological Products
- Guide: Biopharmaceutical Process Development & Manufacturing
- Guide: ATMPs - Autologous Cell Therapy
Investigational Products (1)
Lifecycle Management (2)
Manufacturing Operations (3)
Quality by Design (1)
Community Discussions
Community Discussions
Mar 28, 2025
Information Systems
Regulatory
Advanced Manufacturing
Artificial Intelligence
Dec 16, 2024
Biotechnology
Containment
Dec 02, 2024
Biotechnology
Pharmaceutical Engineering Magazine Articles
Webinars
White Papers
July / August 2024
The explosive growth of advanced therapy medicinal products (ATMPs), particularly cellular…
May / June 2024
The commercialization of personalized medicine has ushered in demand for a new type of facility—…
November / December 2023
There is much that large-scale commercial stem cell therapy processes can adopt from the existing…
May / June 2022
Realizing the promise of any novel viral vector therapeutic depends on the innovator’s ability to…

Videos
iSpeak Blog Posts
Professional Development Training
Biopharmaceuticals: Webinar C> e ATMP
Biopharmaceuticals: Webinar de treinamento em C> e ATMP Visão geral Este webinar é uma gravação do novo curso de instrutor que é um curso de nível avançado sobre therapies C e Gene T (C>) e Medicamentos de Terapia Avançada (ATMP). O curso também fornece umavisão geral dos componentes mais comuns e estabelecidos que são aproveitados em produtos C> (por exemplo, plasmídeos, mRNA, nanopartículas lipídicas, vetores virais), cobrindo terminologia, processos de fabricação e subsequente caracterização analítica de os componentes fabricados e os produtos terapêuticos. As plataformas de células T…
Produtos Biofarmacêuticos: Aspectos CMC
Modo de Entrega: Webinar Produtos Biofarmacêuticos: Webinar de Treinamento sobre Aspectos CMC Visão geral Este webinar é uma gravação do novo curso de instrutor, que é um curso de nível avançado sobre aspectos de Química, Fabricação e Controle (CMC) do desenvolvimento biofarmacêutico. O objetivo deste curso é fornecer uma compreensão avançada dos aspectos CMC de biofármacos desde o desenvolvimento até a comercialização. O que você vai aprender Visão geral do desenvolvimento biofarmacêutico Qualidade por Design (Quality by Design – QbD) Linhagem Celular e Desenvolvimento a Montante (Upstream)…
Produtos Biofarmacêuticos: Webinar de Introdução a Grandes Moléculas
Modo de Entrega: Webinar Produtos Biofarmacêuticos: Webinar de Introdução a Grandes Moléculas Visão geral Este webinar é uma gravação do novo curso ministrado por instrutores que introduz os participantes ao desenvolvimento de biofármacos e abordará conceitos que destacam as diferenças entre moléculas pequenas e biomoléculas (moléculas grandes). O objetivo deste curso é fornecer uma compreensão fundamental dos aspectos CMC de produtos biofarmacêuticos, desde o desenvolvimento até à comercialização. Instrutor O que você vai aprender Desenvolvimento de CMC para Produtos Biofarmacêuticos…
On Demand Biopharmaceutical Three-Part Bundle Series
$775 Savings by Purchasing All Three Courses Overview ISPE is presenting a three-part series that will focus on an introduction to Large Molecules and the Chemistry, Manufacturing, and Controls (CMC) aspects of biopharmaceutical development with an emphasis on how they differ from traditional small molecule pharmaceutical development. The bundle also provides an overview of the most common and established components that are leveraged in C> products (e.g. plasmids, mRNA, lipid nanoparticles, viral vectors), covering terminology, manufacturing processes and subsequent analytical…
Biopharmaceuticals: C> and ATMP
Biopharmaceuticals: C> and ATMP Training Course Overview This new instructor lead course is an advanced level course on Cell and Gene Therapies C> and Advanced Therapy Medicinal Products (ATMP). The course provides an overview of the most common and established components that are leveraged in C> products (e.g. plasmids, mRNA, lipid nanoparticles, viral vectors), covering terminology, manufacturing processes and subsequent analytical characterization of the manufactured components and therapeutic products. The adeno-associated virus (AAV) and chimeric antigen receptor (CAR) T-cell…











c85f.png?itok=XIRSIZ3u)